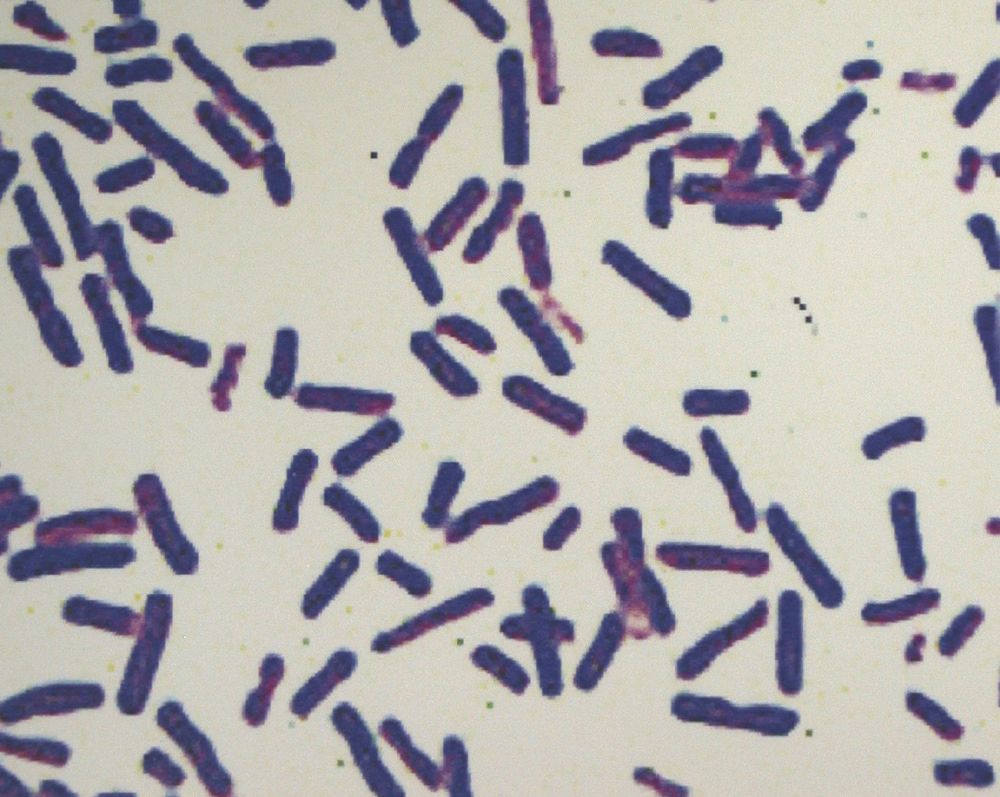
【第三十九讲】李斯特菌:吃出来的脑膜炎_治疗

短杆菌

短小杆菌属_百度百科
图片尺寸268x279
泥鳅经常涨肚,全身红点的原因分析和处理方法_淡水养殖(泥鳅养殖)_中
图片尺寸640x482
黄色短杆菌_北京北纳bncc335829_技术参数_价格-仪器网
图片尺寸371x212
臭脚辣眼睛的精华,可能也是美食里你最爱的那一味_荔枝网新闻
图片尺寸550x432
【第三十九讲】李斯特菌:吃出来的脑膜炎_治疗
图片尺寸1000x797
方便了,余庆县中医院皮肤科可以做真菌检测啦!_手机搜狐网
图片尺寸640x625
婀娜多姿的细菌(第二部分)---抗生素作用下细菌的模样_网易订阅
图片尺寸600x569
高中生物知识点精析——遗传的分子基础_细菌
图片尺寸1024x640
m-16v到底有什么作用?_手机搜狐网
图片尺寸300x266
记录一下实验室生活
图片尺寸1080x1072
婀娜多姿的细菌(第二部分)---抗生素作用下细菌的模样_网易订阅
图片尺寸600x600
短棒状杆菌菌苗(疾病)_技点百科
图片尺寸864x1200
201510312295.0 - 一株短小芽孢杆菌n103‑1及其应用 - soopat专利
图片尺寸1000x990
【创建国家卫生县城】密封腌渍食物中暗藏健康隐患,需谨慎防范_腾讯新
图片尺寸400x299
新的短短芽孢杆菌菌株,培养方法及其应用技术,苏云金芽孢杆菌菌株专利
图片尺寸880x734
一种短小芽孢杆菌及其在镉污染修复中的应用制造技术,土壤镉污染专利_
图片尺寸995x1000
白喉是什么呢?该怎样预防?_公众健康教育_陕西百姓健康网
图片尺寸527x457
clitocybe rivulosa (pers. : fr.) kummer
图片尺寸800x533
黄色短杆菌 - 搜狗百科
图片尺寸300x240
单核细胞增生李斯特氏菌检验解决方案-环凯微生物官网
图片尺寸401x302